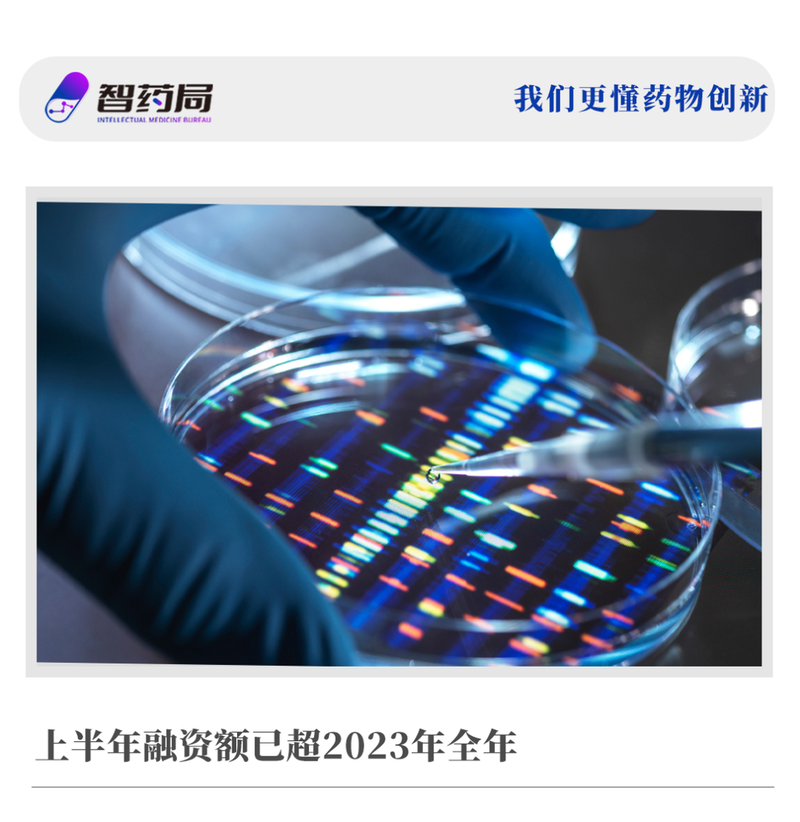
图片

2024年的生物科技IPO和并购热,市场回来了?
2024年8月17日
近日,汇丰创新银行发布了一份报告,分析了2024年上半年全球医疗健康领域的风险投资与退出活动,特别是美国和欧洲市场的情况。研报指出,与2023年相比,2024年生物制药的投资活动出现了明显的反弹,生物医药投资回暖。研报中表示,无论是退出还是融资数量,2024年上半年都已经和2023年全年持平,并且有望追赶到2022年的水平。有业内人士认为,可以确信最坏的情况已经过去了,如今发生的一些趋势正朝着正确的方向发展。退出是投资的指挥棒,同时也是生物技术行业健康状况的重要指标,已经显示出复苏的迹象。2024年上半年,共有10家biotech成功上市,几乎已经和2023年全年的数量持平,同时有望恢复到2022年的水平。尽管IPO数量无法和巅峰时期的2020年和2021年相比较,但毫无疑问今年的IPO数量将持续回暖和复苏。GG Oncology在上市首日迎来了大涨95.63%,给当时的生物医药来了一剂强心剂。不过后续的IPO没能继续GG Oncology的上扬趋势。业内人士认为,可以确信最坏的情况已经过去了,如今发生的一些趋势正朝着正确的方向发展。同样作为另一大退出渠道的并购活动也非常强劲,尤其是针对在过去几年里完成IPO的上市生物科技公司。由于市场环境变化,不少公司的估值跌去了一大半。这意味着公司和投资者都对估值投降,并认为2024年是强劲的并购年。于是可以看到,今年上半年的并购数量远超去年一整年,大型制药公司是其中的主要参与者,以合适的价格补充其产品管线。因此无论是并购数量还是并购额,都相较于2023年大幅度增加,超过10亿美元的并购超过7笔。典型的案例是GSK(葛兰素史克)斥资14亿美元收购Aiolos,其核心管线——靶向 TSLP的长效抗体AIO-001来自恒瑞医药。此外,默沙东宣布耗费30亿美元收购眼科医药公司eyeBio、艾伯维收购Landos Biopharma和Celsius Therapeutics等。投资表现强劲,早期交易卷土重来
得益于强劲的IPO和并购交易,2024年的生物医药融资额大幅增加,上半年的融资总金额已经超过2023年全年的总金额,而且出现了大量由投资者主导的新融资。下图可以直观看到,2023年生物医药仅有161起总计40亿美元的融资,而仅在2024年,就有71笔总计超过52亿美元的融资。虽然许多公司仍然依赖于日益减少的融资资金,需要找到一个新的领投人,否则将面临整合或关闭,但该行业基本上摆脱了2023年的低迷。在市场低迷的时期,投资人偏向于投向那些有临床资产的公司,尤其是位于II期临床的药物,市场恢复下,临床前公司的早期交易又卷土重来。在2024年上半年,早期交易占主导地位,占交易活动的73%(60%临床前;13%1期),与2023年的77%类似。而这些交易的估值有1.3倍的中位数涨幅。细分领域中,平台型公司交易金额上升,但交易数量下降;肿瘤学和神经学投资飙升,而交易保持稳定。肿瘤学的投资在第二季度达到了一年多以来的高点,有 15 笔首次融资交易。代谢性、自身免疫性疾病在大量病例中出现激增。2024年上半年,几笔巨额交易在代谢和自身免疫领域引起了轰动,其中Hercules(4亿美元)、Metsera(3.5亿美元)和Mirador(4亿美元),2024年上半年,孤儿药和罕见病领域没有进行首次融资交易。不过,首轮融资的交易正在下滑,即种子轮和天使轮的估值开始下降。2024年上半年种子轮投前估值中位数为1000万美元,低于2023年的1500万美元。A轮预融资为4200万美元,而2023年为5000万美元。其中,七笔超过5000万美元的大型交易,使投资金额超过2023年水平,与2022年上半年的投资金额相接近。值得注意的是, 本篇报告中特意提出了计算生物学公司的融资情况。根据定义,计算生物学公司即须将计算工具应用于治疗、研发工具和诊断领域,以获得新颖的化学或生物学见解的公司,某种意义上和AI制药公司有相当大的重合。整体情况来看,今年上半年共有30笔关于计算生物学+生物医药的交易,总计约26亿美元;而在诊断、临床等领域,也有不少计算优先公司获得青睐。今年上半年融资额Top20的公司中,人工智能+药物研发企业就占据4席,包括Xaira Therapeutics、Formation Bio、Bioage和Enveda。其中起到决定性拉动作用的Xaira Therapeutics,该公司旨在用人工智能赋能药物发现。由ARCH Venture Partners和Foresite Labs联合孵化,由包括 Foresite capital、F-Prime(富达投资旗下)、红杉资本在内的超过12家投资机构为其提供超过10亿美元的承诺资金。此外,Formation Bio完成3.72亿美元的D轮融资,由a16z领投,赛诺菲、红杉资本、Thrive Capital等跟投。此前Formation Bio与赛诺菲、OpenAI达成合作,三方共同构建一款AI驱动的药物开发软件。除开上述4家公司外,还有多家AI制药企业获得超亿美元融资。AI药物发现和精准医疗技术Zephyr AI完成1.11亿美元A轮融资,礼来参与投资;前Meta的蛋白质团队创办的EvolutionaryScale,拿下1.42亿美元超强种子轮;AI赋能抗体开发的Diagonal Therapeutics完成A轮1.28亿美元融资,致力于激动性抗体药物开发;国内AI+药物递送公司剂泰医药获得C轮1亿美元融资,累计融资近3亿美元;
这一轮的投资人中,不仅有相信AI制药的医药投资机构,TMT投资基金,还包括AI霸主,例如英伟达已经投了12家AI制药公司,押注人工智能在医药的革命性浪潮。简而言之,随着IPO市场的复苏,投资人们在生物技术上投入了比以前更多的资金。过去半年,种子轮和A轮融资的数量“显着增加”,让初创公司有了新的融资机会。但另一方面,中国的生物科技融资和欧美国家却出现了温度差,企业融资艰难。想要行业复苏,我们仍然需要更多积极信号。